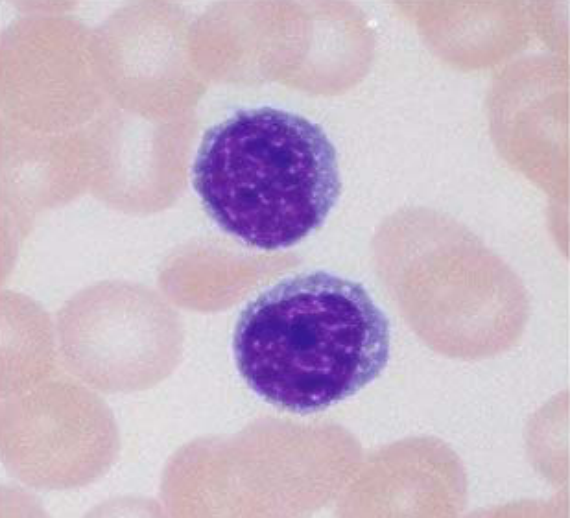

4.3.6 淋巴细胞
-
1 内容
-
2 测验
上一节
下一节
形态
● 血液中大部分为直径 6-8μm的小淋巴细胞,小部分为直径 9-12μm的中淋巴细胞。
● 核呈圆形,一侧常有浅凹,染色质浓密呈块状,着色深。
● 胞质嗜碱性,呈晴空样蔚蓝色。
血细胞仿真图:

淋巴细胞光镜像(Wright-Giemsa,10×40):
淋巴细胞透射电镜像:

分类
1.T细胞:胸腺依赖淋巴细胞,产生于胸腺。
2.B细胞:骨髓依赖淋巴细胞,产生于骨髓。
B细胞→浆细胞→抗体→体液免疫
3.NK细胞:自然杀伤细胞,产生于骨髓。
功能
淋巴细胞是主要的免疫细胞,在机体防御疾病过程中发挥关键作用。


